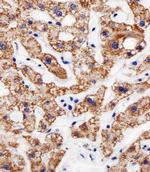
AGAP4 Antibody in Immunohistochemistry (Paraffin) (IHC (P))

Search
Invitrogen
AGAP4 Polyclonal Antibody
{{$productOrderCtrl.translations['antibody.pdp.commerceCard.promotion.promotions']}}
{{$productOrderCtrl.translations['antibody.pdp.commerceCard.promotion.viewpromo']}}
{{$productOrderCtrl.translations['antibody.pdp.commerceCard.promotion.promocode']}}: {{promo.promoCode}} {{promo.promoTitle}} {{promo.promoDescription}}. {{$productOrderCtrl.translations['antibody.pdp.commerceCard.promotion.learnmore']}}
Additional Information:
{{banner.description}}
图: 1 / 5
AGAP4 Antibody (PA5-49343) in ICC/IF
Immunofluorescent analysis of AGAP8 in HeLa cells lysates. Samples were probed with a AGAP8 polyclonal antibody (Product # PA5-49343) at a 1:25 dilution. An Alexa Fluor 488-conjugated goat anti-rabbit lgG at 1:400 dilution was used as the secondary antibody (green). Cytoplasmic actin was counterstained with Alexa Fluor® 555 Phalloidin (red).

产品信息
PA5-49343
应用
建议稀释比
已发表文章
产品规格
宿主/亚型
Rabbit
/ IgG
分类
Polyclonal
类型
Antibody
抗原
KLH conjugated synthetic peptide between 498-531 amino acids from the C-terminal region of human AGAP8.
偶联物
形式
Liquid
浓度
Lot-Specific
保存条件
-20°C, Avoid Freeze/Thaw Cycles
运输条件
Wet ice
RRID
靶标信息
Putative GTPase-activating protein.
仅用于科研。不用于诊断过程。未经明确授权不得转售。
篇参考文献 (0)
您是否在文献中引用过该产品?请点击下方按钮邮件告知我们。



